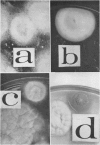
722

Abstract
Evidence is presented in support of the hypothesis that fresh bat guano serves as a means of pathogenic fungi dissemination in caves. A total of 371 guano samples were collected from caves in southeastern New Mexico. Each sample was agitated in sterile saline and sand. The supernatant fluid was treated with an antibiotic and streaked on differential media. Cultures were incubated at 25 and 37 C and examined at intervals over a 4-week period. For animal inoculation, highly concentrated inoculum was injected intraperitoneally into white Swiss mice. Animals were sacrificed 4 weeks later, and portions of their lung, liver, and spleen were cultured on selective media, incubated at 25 C, and examined at intervals over a 4-week period. Microsporum gypseum was isolated at all 10 collecting stations with an incidence of 22.4%, Trichophyton mentagrophytes at 7 stations with an incidence of 5%, T. rubrum at 3 stations with an incidence of 3%, and T. terrestre at 1 station with an incidence of 0.5%. From a total of 60 pools of liver-spleen-lung suspensions, 6 pools yielded positive cultures of Histoplasma capsulatum and 1 pool yielded T. mentagrophytes. No significant difference was found among the different selective media with respect to recovery of dermatophytes. Among the human pathogenic fungi isolated were Candida sp., Cladosporium sp., Coccidioides immitis, Cryptococcus neoformans, H. capsulatum, M. gypseum, T. mentagrophytes, T. rubrum, T. terrestre, and Sporotrichum sp.
Full text
PDF




Images in this article
Selected References
These references are in PubMed. This may not be the complete list of references from this article.
- ALARCON D. G. Histoplasmosis pulmonar epidémica. Gac Med Mex. 1957 Oct;87(10):745–750. [PubMed] [Google Scholar]
- CAMPINS H., ZUBILLAGA C., GOMEZ LOPEZ L., DORANTE M. Estudio de una epidemia de histoplasmosis en el Estado Lara, Venezuela. Gac Med Caracas. 1955 Mar-Apr;62(3-4):85–109. [PubMed] [Google Scholar]
- DE MONTEMAYOR L., HEREDIA OSIO B., DE BELLARD PIETRI E. P. Aislamiento del Histoplasma capsulatum en el suelo de dos cavernas en Venezuela; nuevas técnicas de investigación por método de flotación. Rev Sanid Asist Soc. 1958 Jan-Apr;23(1-2):39–54. [PubMed] [Google Scholar]
- EMMONS C. W. Association of bats with histoplasmosis. Public Health Rep. 1958 Jul;73(7):590–595. [PMC free article] [PubMed] [Google Scholar]
- EMMONS C. W. Isolation of Histoplasma capsulatum from soil in Washington. D.C. Public Health Rep. 1961 Jul;76:591–595. [PMC free article] [PubMed] [Google Scholar]
- EMMONS C. W. Saprophytic sources of Cryptococcus neoformans associated with the pigeon (Columba livia). Am J Hyg. 1955 Nov;62(3):227–232. doi: 10.1093/oxfordjournals.aje.a119775. [DOI] [PubMed] [Google Scholar]
- HOSTY T. S., AJELLO L., WALLACE G. D., HOWELL J., MOORE J. A small outbreak of histoplasmosis. Am Rev Tuberc. 1958 Oct;78(4):576–582. doi: 10.1164/artpd.1958.78.4.576. [DOI] [PubMed] [Google Scholar]
- LITTMAN M. L., SCHNEIERSON S. S. Cryptococcus neoformans in pigeon excreta in New York City. Am J Hyg. 1959 Jan;69(1):49–59. doi: 10.1093/oxfordjournals.aje.a119980. [DOI] [PubMed] [Google Scholar]
- VANBREUSEGHEM R. Technique biologique pour l'isolement des dermatophytes du sol. Ann Soc Belg Med Trop (1920) 1952 Apr 30;32(2):173–178. [PubMed] [Google Scholar]
- ZEIDBERG L. D., AJELLO L. Environmental factors influencing the occurrence of Histo-plasma capsulatum and Microsporum gypseum in soil. J Bacteriol. 1954 Aug;68(2):156–159. doi: 10.1128/jb.68.2.156-159.1954. [DOI] [PMC free article] [PubMed] [Google Scholar]